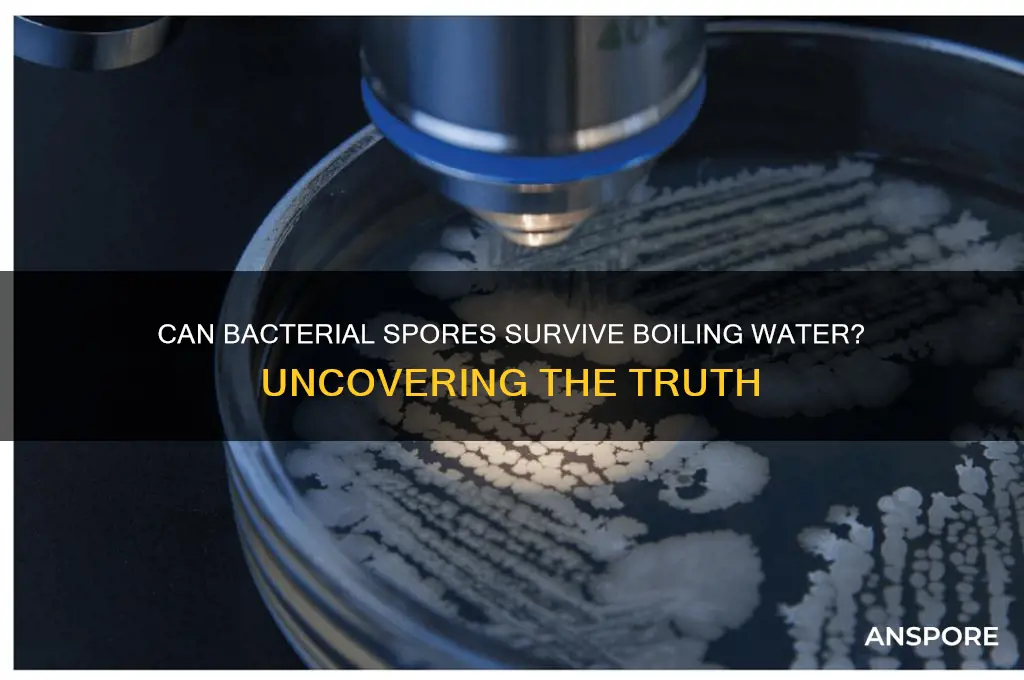
can bacterial spores survive boiling water

Bacterial spores are highly resistant structures produced by certain bacteria to survive extreme environmental conditions, including heat, desiccation, and chemicals. One common question is whether these spores can withstand boiling water, a method often used for sterilization. Boiling water reaches temperatures of 100°C (212°F), which is typically sufficient to kill most vegetative bacteria but may not always eliminate spores. Some bacterial spores, such as those of *Clostridium botulinum* and *Bacillus* species, are known to survive boiling for extended periods, requiring higher temperatures or longer exposure times to ensure complete inactivation. Understanding the resilience of bacterial spores in boiling water is crucial for food safety, medical sterilization, and other applications where thorough disinfection is essential.
| Characteristics | Values |
|---|---|
| Survival in Boiling Water | Many bacterial spores can survive boiling water (100°C/212°F) for several minutes to hours, depending on the species. |
| Examples of Resistant Spores | Clostridium botulinum, Bacillus cereus, Clostridium perfringens. |
| Minimum Lethal Time at 100°C | Varies; e.g., C. botulinum spores may survive up to 4 hours, while others may be killed in 10–30 minutes. |
| Factors Affecting Survival | Spore age, species, water pH, presence of salts or other solutes, and container material. |
| Recommended Method for Destruction | Pressure cooking at 121°C (250°F) for 15–30 minutes (autoclaving) or boiling for extended periods (e.g., 30–60 minutes). |
| Common Applications | Food preservation (canning), medical sterilization, and laboratory research. |
| Risk in Food Safety | Improperly processed canned foods can harbor surviving spores, leading to foodborne illnesses like botulism. |
| Resistance Mechanism | Spores have a thick, protective coat and low water content, making them highly resistant to heat and desiccation. |
| Latest Research (as of 2023) | Studies continue to explore spore resistance in extreme conditions, with focus on improving sterilization methods. |
Explore related products
What You'll Learn
- Heat Resistance Mechanisms: How spores protect DNA and proteins from extreme temperatures
- Boiling Time Impact: Duration needed to kill spores in boiling water
- Species Variability: Differences in spore survival among bacterial species
- Practical Applications: Using boiling water for sterilization and spore inactivation
- Survival Post-Boiling: Conditions allowing spores to revive after boiling

Heat Resistance Mechanisms: How spores protect DNA and proteins from extreme temperatures
Bacterial spores are renowned for their ability to withstand extreme conditions, including boiling water, which typically reaches temperatures of 100°C (212°F). This remarkable resilience is not accidental but the result of sophisticated heat resistance mechanisms that protect their DNA and proteins. Understanding these mechanisms provides insight into how spores can survive environments that would destroy most other life forms.
One key mechanism involves the formation of a protective spore coat, composed of multiple layers of proteins, peptidoglycan, and other polymers. This coat acts as a physical barrier, reducing the penetration of heat and other damaging agents. Additionally, the core of the spore contains high levels of calcium dipicolinate, a compound that binds water molecules and stabilizes the DNA and proteins, preventing denaturation at high temperatures. This chemical fortification is crucial for maintaining the structural integrity of essential biomolecules.
Another critical factor is the low water content within the spore core, achieved through a process called dehydration. By minimizing free water, spores reduce the likelihood of heat-induced damage, such as protein unfolding or DNA strand separation. This desiccated state also slows metabolic activity, further conserving energy and resources during dormancy. Rehydration occurs only when conditions become favorable, ensuring survival until then.
Spores also employ DNA repair mechanisms that activate upon exposure to heat. For instance, the presence of small, acid-soluble proteins (SASPs) in the spore core binds to DNA, protecting it from thermal degradation. These proteins act as molecular shields, preventing DNA damage and ensuring genetic material remains intact. Once the spore germinates, these proteins are degraded, allowing normal cellular functions to resume.
Practical applications of this knowledge are vast. For instance, in food preservation, understanding spore resistance helps develop more effective sterilization techniques, such as autoclaving at 121°C (250°F) for 15–20 minutes, which is necessary to kill even the most heat-resistant spores. Similarly, in medical settings, this knowledge informs sterilization protocols for surgical instruments, ensuring the elimination of spore-forming pathogens like *Clostridium botulinum* and *Bacillus anthracis*. By targeting these mechanisms, we can design strategies to combat spore survival in critical environments.
In summary, bacterial spores employ a combination of physical barriers, chemical stabilizers, dehydration, and DNA repair mechanisms to protect their genetic material and proteins from extreme temperatures. This multifaceted defense system explains their ability to survive boiling water and other harsh conditions, offering both scientific fascination and practical implications for industries ranging from food safety to healthcare.
Do Fungi Produce Spores Above Ground? Exploring Fungal Reproduction
You may want to see also

Boiling Time Impact: Duration needed to kill spores in boiling water
Bacterial spores are notoriously resilient, capable of withstanding extreme conditions that would destroy most other microorganisms. When it comes to boiling water, the question of how long it takes to kill these spores is critical for ensuring water safety. Research indicates that while boiling water is effective against many pathogens, the duration required to eliminate bacterial spores can vary significantly depending on the species and environmental factors.
From an analytical perspective, the heat resistance of bacterial spores is measured in terms of their D-value, which represents the time required at a specific temperature to reduce the spore population by 90%. For example, *Clostridium botulinum* spores, a common concern in food preservation, have a D-value of approximately 0.2 minutes at 100°C (212°F). This means that after 0.2 minutes of boiling, 90% of the spores are inactivated. However, achieving complete sterilization requires multiple D-values, typically 6 to 12, to ensure a 99.9999% reduction. For *C. botulinum*, this translates to 1.2 to 2.4 minutes of boiling. Practical guidelines often recommend boiling water for at least 1 minute at altitudes below 6,500 feet and 3 minutes at higher elevations to account for lower boiling points and spore variability.
Instructively, boiling water for spore inactivation is not a one-size-fits-all process. For instance, *Bacillus cereus* spores, commonly found in soil and food, are more heat-resistant than *C. botulinum*. Studies suggest that boiling for 10 minutes is necessary to ensure their complete destruction. To maximize effectiveness, bring water to a rolling boil, maintain this temperature for the recommended duration, and allow it to cool naturally. Using a thermometer can help verify that the water reaches 100°C, especially in areas with high altitudes or unreliable stovetops.
Persuasively, while boiling is a reliable method for killing bacterial spores, it is not always the most practical or energy-efficient solution, particularly in resource-limited settings. Alternatives such as chemical disinfectants (e.g., chlorine) or filtration systems (e.g., ceramic filters with pore sizes <1 micron) can be effective against spores without requiring prolonged heating. However, boiling remains the gold standard for emergency situations where other methods are unavailable. Its simplicity and accessibility make it a vital tool for water purification, especially during natural disasters or outdoor activities.
Comparatively, the boiling time required for spore inactivation contrasts sharply with that needed for vegetative bacteria, which are typically eliminated within seconds of reaching boiling temperatures. This disparity underscores the evolutionary adaptations of spores, which include a thick protein coat and DNA repair mechanisms. For example, *Geobacillus stearothermophilus*, a spore-forming bacterium used in sterilization validation, requires exposure to 121°C for 15 minutes in an autoclave—conditions far beyond what boiling water can achieve. This highlights the importance of understanding the specific spore type and adjusting treatment times accordingly.
In conclusion, the duration needed to kill bacterial spores in boiling water depends on the spore species, boiling temperature, and environmental conditions. While 1 to 3 minutes of boiling is generally sufficient for common spores like *C. botulinum*, more resistant types may require up to 10 minutes. Practical tips, such as maintaining a rolling boil and verifying temperature, can enhance effectiveness. For those seeking alternatives, chemical or filtration methods offer viable options, though boiling remains a dependable choice in emergencies. Understanding these nuances ensures that water treatment practices are both safe and efficient.
Are Water Bottle Bacteria Spores Poisonous? Uncovering the Truth
You may want to see also

Species Variability: Differences in spore survival among bacterial species
Bacterial spores exhibit remarkable resilience, but their survival in boiling water varies significantly across species. For instance, *Clostridium botulinum* spores can endure temperatures of 100°C for several minutes, while *Bacillus subtilis* spores may survive up to 20 minutes under the same conditions. This variability underscores the importance of understanding species-specific resistance when designing sterilization protocols.
To illustrate, consider the food industry, where boiling is a common method to eliminate pathogens. While *Bacillus cereus* spores are inactivated after 10–15 minutes of boiling, *Clostridium perfringens* spores require at least 20 minutes. This difference necessitates precise time-temperature combinations to ensure safety. For home canning, the USDA recommends boiling low-acid foods (e.g., vegetables) for 20–30 minutes to target the most heat-resistant spores, such as those of *Clostridium botulinum*.
Analyzing the mechanisms behind this variability reveals that spore coat composition and core hydration levels play critical roles. Species like *Deinococcus radiodurans*, known for extreme radiation resistance, also demonstrate enhanced heat tolerance due to their unique DNA repair mechanisms. Conversely, *Escherichia coli*, a non-spore-forming bacterium, is rapidly killed by boiling water, highlighting the evolutionary advantage of sporulation in certain environments.
Practical implications of species variability extend beyond food safety. In healthcare, autoclaves use steam at 121°C for 15–30 minutes to sterilize equipment, targeting the most resilient spores, such as *Geobacillus stearothermophilus*. However, in water treatment, boiling for 1 minute effectively inactivates most pathogens, except for highly resistant spores like *Bacillus anthracis*, which may require additional measures such as filtration or chemical disinfection.
In conclusion, recognizing species-specific differences in spore survival is essential for effective sterilization. Whether in food processing, healthcare, or water treatment, tailoring methods to the most resistant species ensures safety and efficiency. For example, when boiling water for drinking in areas with potential *Bacillus anthracis* contamination, extending boiling time to 3–5 minutes provides an added safety margin. This targeted approach transforms a simple process into a robust defense against microbial threats.
Are Magic Mushroom Spores Legal in Texas? A Comprehensive Guide
You may want to see also
Explore related products

Practical Applications: Using boiling water for sterilization and spore inactivation
Boiling water is a widely recognized method for sterilizing objects and inactivating many microorganisms, but its effectiveness against bacterial spores is a critical consideration in various practical applications. Bacterial spores, such as those from *Clostridium botulinum* and *Bacillus anthracis*, are notoriously resistant to extreme conditions, including heat. While boiling water (100°C or 212°F) can kill vegetative bacteria within minutes, spores often require prolonged exposure to higher temperatures or additional methods for complete inactivation. This distinction is essential in fields like food preservation, medical sterilization, and environmental decontamination.
In food preservation, boiling water is commonly used for canning and blanching, but it is insufficient for destroying bacterial spores in low-acid foods like vegetables and meats. For instance, *Clostridium botulinum* spores can survive boiling for hours, posing a risk of botulism if not properly addressed. To ensure safety, the USDA recommends pressure canning at temperatures above 121°C (250°F) for at least 30 minutes, which effectively destroys spores. Home canners must follow precise instructions, including processing times and pressure settings, to avoid contamination. Boiling water alone is inadequate for this purpose, highlighting the need for supplementary techniques.
Medical and laboratory settings employ boiling water as a preliminary sterilization step, but it is rarely the sole method for spore inactivation. Autoclaves, which use steam under pressure to reach temperatures of 121°C to 134°C (250°F to 273°F), are the gold standard for sterilizing surgical instruments and lab equipment. Boiling water can be used for decontaminating non-critical items, such as glassware or metal tools, but only after thorough cleaning and followed by drying to prevent recontamination. For heat-sensitive materials, alternative methods like chemical disinfectants or low-temperature plasma sterilization may be more suitable, emphasizing the limitations of boiling water in specialized contexts.
In environmental decontamination, boiling water is impractical for large-scale applications but can be useful in emergency situations or resource-limited settings. For example, during waterborne disease outbreaks, boiling drinking water for at least one minute (three minutes at high altitudes) effectively kills most pathogens, including vegetative bacteria. However, this method does not guarantee spore inactivation, particularly for *Bacillus* and *Clostridium* species. In such cases, filtration or chemical treatment (e.g., chlorine or iodine) should be combined with boiling to ensure comprehensive disinfection. Practical tips include using a clean container, covering the water during boiling to prevent recontamination, and allowing it to cool naturally before use.
While boiling water is a simple and accessible sterilization method, its limitations against bacterial spores necessitate careful application and often supplementary techniques. Understanding these constraints ensures its effective use in food safety, medical practices, and emergency preparedness. By combining boiling with other methods, such as pressure canning, autoclaving, or chemical treatment, individuals and professionals can achieve reliable spore inactivation, safeguarding health and hygiene in diverse scenarios.
Exploring Multicellular Spore Producers: Are They Diploid Organisms?
You may want to see also

Survival Post-Boiling: Conditions allowing spores to revive after boiling
Bacterial spores, such as those from *Clostridium botulinum* and *Bacillus cereus*, are renowned for their resilience, capable of withstanding extreme conditions, including boiling water. However, survival post-boiling is not guaranteed; it hinges on specific conditions that allow spores to revive. Understanding these conditions is crucial for industries like food preservation and medical sterilization, where complete spore eradication is essential.
Temperature and Duration: The Foundation of Spore Inactivation
Boiling water (100°C or 212°F) is effective at killing vegetative bacteria but less so for spores. Studies show that bacterial spores require prolonged exposure to boiling temperatures to be inactivated. For instance, *Clostridium sporogenes* spores need at least 5 minutes of boiling to achieve a 10^6 reduction in viability. However, even after boiling, some spores may enter a dormant state rather than die outright. If these spores are later exposed to favorable conditions—such as nutrient-rich environments and temperatures between 25°C and 37°C—they can germinate and revive, posing risks in food or medical settings.
Environmental Factors: The Catalysts for Revival
Post-boiling survival often depends on the environment spores encounter after exposure. For example, spores in a dry, sterile environment are less likely to revive compared to those in moist, nutrient-rich conditions. In food processing, residual nutrients or organic matter can provide the energy needed for spore germination. Similarly, pH levels play a role; spores of *Bacillus subtilis* are more likely to revive in neutral to slightly alkaline environments (pH 6.5–8.5). Practical precautions, such as combining boiling with other methods like autoclaving (121°C for 15–30 minutes) or adding antimicrobial agents, can mitigate revival risks.
Practical Tips for Preventing Post-Boiling Revival
To ensure spores do not revive after boiling, follow these steps: First, maintain boiling temperatures for at least 10 minutes, especially when dealing with high spore loads. Second, combine boiling with physical removal techniques, such as filtration or centrifugation, to eliminate spores from the medium. Third, store boiled materials in sterile, airtight containers to prevent recontamination. For food preservation, consider adding preservatives like sodium benzoate or using fermentation processes that create unfavorable conditions for spore germination.
Comparative Analysis: Boiling vs. Alternative Methods
While boiling is accessible and cost-effective, it falls short compared to methods like autoclaving or chemical sterilization in ensuring complete spore inactivation. Autoclaving, for instance, uses steam under pressure (121°C) to penetrate spore coats, achieving a 10^6 reduction in viability within 15–30 minutes. Chemical agents like hydrogen peroxide or formaldehyde are also effective but require careful handling. Boiling remains a viable option for low-risk applications, but its limitations highlight the need for tailored approaches in high-stakes scenarios like medical sterilization or large-scale food production.
Takeaway: Balancing Practicality and Efficacy
Boiling water can reduce spore populations but is not foolproof for complete eradication. Survival post-boiling depends on factors like temperature duration, environmental conditions, and post-treatment handling. For critical applications, combining boiling with additional methods ensures safety. In everyday contexts, such as home canning, adhering to strict protocols—like boiling jars and lids for 10 minutes before use—minimizes revival risks. Ultimately, understanding the conditions that allow spores to revive empowers better decision-making in both industrial and domestic settings.
Rainstorms and Airborne Spores: Can Heavy Downpours Cleanse the Air?
You may want to see also
Frequently asked questions
Yes, bacterial spores, such as those from *Clostridium botulinum* and *Bacillus* species, can survive boiling water for several minutes. Boiling is not sufficient to kill them.
Bacterial spores can survive in boiling water (100°C/212°F) for up to 10–20 minutes or longer, depending on the species and conditions.
Bacterial spores require temperatures of 121°C (250°F) or higher, typically achieved through autoclaving (pressure cooking), to be effectively killed.
No, boiling water does not make bacterial spores safe for consumption. They remain viable and can germinate under favorable conditions, potentially causing illness.
Effective methods include autoclaving (121°C under pressure), chemical sterilization using agents like bleach or hydrogen peroxide, or filtration with a spore-rated filter.































